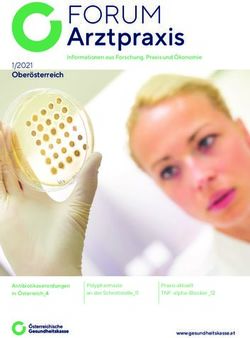
FORUM Arztpraxis 1/2021 Ober&ouml;sterreich - &Ouml;GK

Belgien-Magazin - Aachener Zeitung
←
→
Transkription von Seiteninhalten
Wenn Ihr Browser die Seite nicht korrekt rendert, bitte, lesen Sie den Inhalt der Seite unten
Belgien-Magazin
Samstag, 24. März 2018
Anzeigensonderveröffentlichung
Unglaubliche Entdeckungen Römische Geschichte in Lüttich Raumfahrt zum Anfassen und Ausprobieren
Eine spannende Ostertour durchs Land von Theux Neue Ausstellung im Museum La Boverie Das Space-Center in den Wäldern der Ardennen
Ausgabe ABCDE
Foto: (c) R. Minderjahn
Hotel
Bonhomme
Remouchamps
Grand- „2030
Sportlich
Hornu- werde ich
aktiv
Mine 20 sein“
Ausstellung/
Bahnhof Lüttich
r
hle
_Bic Expo
Foto: Thomas Foto: Europa
ant
Foto: GuyFoc
Ein Produkt aus dem2 Anzeigensonderveröffentlichung
Grand-Hornu, im Herzen der Provinz Hennegau gelegen, ist eines der besten Beispiele für neoklassisches Industrie-Erbe in Europa. Der Komplex wurde im 19.
Jahrhundert von Henri De Gorge, einem französischen Unternehmer, erbaut. Foto: Isabelle Harsin
Flanieren und Kunstgenuss in großem Industrieerbe
Die ehemalige Bergbau-Hochburg Grand-Hornu wurde zu einer sehenswerten Industrie-Kulturstätte errichtet
Von Rolf MindeRjahn Viereckanlage, in der Mitte runter wurden Dampfmaschi- „Otchi Tchiornie“ – 04.03.2018 dient das nicht der Vermitt-
eine Baumgruppe, an seiner nen hergestellt, aber auch Lo- bis 03.06.2018 lung von Hoffnungslosigkeit,
Aus Grand-Hornu wird der Be- linken Seite befinden sich die ren, Werkzeuge und Feuer- Das Ausstellungsprogramm sondern einem Wachrütteln
sucher viele Eindrücke von ehemaligen Stallungen für die wehrpumpen. im MAC‘s für das Jahr 2018 dafür, dass wir eine noch be-
der Bedeutung dieser indus- zahlreichen Grubenpferde so- beginnt mit einem der welt- stehende Wahlfreiheit dafür
triellen Anlage für den dama- wie eine Schmiede und eine MAC’s – Museum für weit am meisten gefragten haben, uns zwischen morbi-
ligen Wohlstand der Region, Kupferschmiede. Am anderen moderne Kunst zeitgenössischen französi- der Desillusion und der Freude
aber auch für den technischen Ende gelangt man durch schen Künstler: Adel Abdesse- am Leben zu entscheiden. Die
Fortschritt allgemein mitneh- einen weiteren Toreingang Seit 2002 befindet sich in med. Der für seine frappieren- Ausstellung in Grand-Hornu
men, verbunden mit einem zum ovalen Haupthof, der wie einem neuen Gebäude das den Skulpturen (beispiels- wurde vom Künstler in einer
sehr interessanten architekto- ein Amphitheater wirkt. Um Museum für moderne Kunst weise „der Kopfstoß“ von Zi- Art Manifest gegen die Barba-
nischen Erbe, das in dieser den Haupthof herum und da- (MAC’s), indem mehrmals dane bei der Fußballweltmeis- rei und für die Freiheit konzi-
Komplexität einzigartig in rüber hinaus sind in Viereck- jährlich Ausstellungen mit terschaft 2006) bekannte piert. Ein roter Teppich (Sym-
Nordeuropa ist. Grand-Hornu anlage die langen Reihen der Werken berühmter zeitgenös- Künstler wird in Grand-Hornu bol für die offizielle Autorität)
liegt vor den Toren von Mons Arbeitersiedlung zu sehen. Sie sischer Künstler organisiert eine „Ausstellung mit Mani- liegt entlang des Rundgangs
im wallonischen Hennegau. hatte für die damalige Zeit ein werden. Es zeigt rund 300 festcharakter“ präsentieren, aus und die Ausstellung be-
Die Anlage wurde vom Indus- außergewöhnliches Ausmaß Kunstwerke in der Daueraus- die hauptsächlich mit neuen ginnt mit einem absurden
triellen Henri De Gorge zwi- mit 450 Häusern. Auf der lin- stellung. Ein wunderbarer und speziell für Grand-Hornu Werk, unsere Ratlosigkeit
schen 1810 und 1830 erbaut. ken Seite des Platzes steht ein Spagat zwischen alt und mo- realisierten Werken bestückt gegenüber dem Krieg betref-
Man betritt diese geschichts- großes Fabrikgebäude mit der dern, in verschiedenen Räu- ist. Adel Abdessemeds Œuvre fend, mit einer „Kamikaze-
beladene Anlage von 10 000 ehemaligen Werkstätte für men, darunter der lange Salle- ist geprägt vom Ausdruck der taube“, die auf einer öffentli-
qm Fläche durch das Ein- Maschinenbau. Bemerkens- Pont mit längslaufenden Leiden in der Welt, vom Ge- chen Bank hockt, wo man zö-
gangstor mit drei Rundbögen wert sind die erhalten geblie- Oberlichtern. waltpotenzial, von Terror und gern wird, sich daneben zu
und vorstehendem Dreieck- benen Säulen, welche Pen- Heuchelei. Wenn der Künstler setzen.
giebel. Es folgt ein Vorhof in dentifkuppeln stützten. Da- Ausstellung Adel Abdessemed uns zu erschüttern scheint, so Fortsetzung auf Seite 3
Der Künstler Adel Abdessemed zeigt im MAC‘s – Museum für moderne Kunst speziell für Grand-
Hornu realisierte Werke. Foto: Ph. de GobertAnzeigensonderveröffentlichung
3
Die Ausstellung „Together! Die Neue Architektur der Gemeinschaft“ beleuchtet das Thema Le Grand-Hornu, Unesco Welterbe-Stätte, jetzt Industriemu-
Bauen und Wohnen im Kollektiv. Foto: Hertha Hurnaus seum und Kunstmuseum. Foto: WBT/Ricardo de la Riva
CID – Zentrum für Together! – Ausstellung zum lektiv. „Together! Die Neue Jahrhunderts bis hin zur Hip- schaftliche Brisanz des The-
Innovation und Design Thema „Die Neue Architektur Architektur der Gemein- pie- und Hausbesetzerszene, mas nimmt: Filme zeigen his-
der Gemeinschaft“– 25.3. bis schaft“ ist die erste Ausstel- die mit dem Slogan „Make torische Protestbewegungen
Dieser Ausstellungsbereich 1.7.2018 lung, die dieses Thema umfas- love, not lofts“ antrat. für Wohnraum, während
dient der Förderung zeitge- Wohnraum ist eine knappe send beleuchtet und räumlich Transparente über die damals
nössischen Designs, einer Kul- Ressource. Die Immobilien- erfahrbar macht. Anhand von Blick auf die Geschichte entwickelten Lösungsansätze
tur des Dialogs zwischen Krea- preise in den Metropolen stei- Modellen, Filmen und Woh- informieren.
tiven und Bürgern. gen, klassische Konzepte des nungen im Maßstab 1:1 prä- Die Ausstellung beginnt mit Eine Installation aus 21
Mittels medialer Aktivitäten Wohnungsbaus können dem sentiert sie eine Vielzahl von einem Blick auf die Ge- großformatigen Modellen
werden Innovation, experi- Bedarf nicht mehr gerecht Beispielen aus Europa, Asien schichte sozialer Wohnideale, heutiger Wohnbauprojekte
mentelle Forschung und das werden. Diese Herausforde- und den USA. Historische Vor- die zumeist aus einem Protest bildet den zweiten Bereich der
Aufkommen neuer Themati- rungen haben eine stille Revo- läufer veranschaulichen zu- gegen bestehende Verhält- Ausstellung. Die gezeigten
ken in den Bereichen Design, lution in der zeitgenössischen gleich die Geschichte der ge- nisse entstanden sind. Dies Beispiele stammen unter an-
Architektur und Grafik geför- Architektur ausgelöst: das meinschaftlichen Architektur unterstreicht eine Inszenie- derem aus Berlin, Zürich, Los
dert. Bauen und Wohnen im Kol- – von den Reformideen des 19. rung, die Bezug auf die gesell- Angeles, Tokio und Wien.4 Anzeigensonderveröffentlichung
Auf dem Markt in Theux befindet sich ein prächtiges Bürgerhaus, dessen Fassade aus Backsteinen und Blaustein besteht. Fotos: Rolf Minderjahn
Abwechslungsreiche Ostertour im Land von Theux
Die typischen Ardennen liegen so nah. Ausflugsziele für die Familie, unglaubliche Entdeckungen und Kuriositäten.
Von Rolf MindeRjahn Die Gemeinde besteht aus du Château” (Restaurant,
einer Reihe schmucker Dör- Snackkarte, Picknick-Erfri-
Karfreitag ist in Belgien kein fer und verwinkelter Weiler schungen, schattige Terrasse
Feiertag. Eine ideale Gele- rund um die Burg von Fran- mit Burgblick) kann man sei-
genheit für einen Osteraus- chimont nahe Spa am Kreuz- nen Aufenthalt angenehm
flug ins Nachbarland abseits weg des Herver Landes und ausklingen lassen. Das Châ-
des Rummels an den eigent- des Ardenner Plateaus. Fran- teau ist Schauplatz des größ-
lichen Ostertagen. Nahe an chimont, ein Bollwerk über ten mittelalterlichen Festes
der deutschen Grenze liegt drei Täler, gilt als seltenes und Marktes in Benelux mit
das Tal der Amel (frz. Am- Beispiel der Entwicklung der 1 500 Teilnehmern in Kostü-
blève). Eine teils abenteuerli- Festungen in der Renais- men (in den ungeraden Jah-
che Region, die sich durch sance. Das acht Kilometer ren). Zurück nach Theux.
viele reizvolle Freizeitange- von Spa gelegene Franchi- Hier fallen die ungewöhn-
bote (vor allem auch für Fa- mont war einst eines der Be- lich vielen schönen alten
milien mit Kindern) und ihre festigungswerke des Fürstbis- Bürgerhäuser aus dem 17.
überraschenden Naturfor- tums Lüttich unter Erard de und 18. Jahrhundert ins
mationen auszeichnet. Ar- la Marck. Von einem Felsvor- Auge. Sie sind wunderbar er-
dennen pur – wie sie nicht sprung aus überragt es gleich halten geblieben. Dazu zählt
nur Wanderer und Naturlieb- drei malerische Täler im Nor- auch das Rathaus an der Ecke
haber schätzen. Das Nadel- den der Ardennen. Ihre Rui- des Marktplatzes aus dem
öhr in die Ardennen ist die nen zeugen noch heute von Jahre 1770 mit schmiede-
Autobahn E 40 Aachen-Lüt- der Wehrhaftigkeit dieser eisernem Geländer und dop-
tich. Man verlässt die Bahn mittelalterlichen Burg, die pelläufiger Treppe. Schmuck-
bei der Abfahrt Verviers/Trè- im 16. Jahrhundert mit stück auf dem Marktplatz ist
ves (Trier) und wechselt in einem kanonenbestückten der sogenannte Perron, den
diese Richtung auf die E 42. Festungswall umgeben ein großer Pinienzapfen ziert
Durch Verviers über die wurde. Die sehenswerten Ka- und ein schmiedeeisernes
Stadtautobahn fährt man an sematten mit ihren unterir- Kreuz. Die Säule aus dem
der Ausfahrt 7 Theux ab und dischen Gängen sind noch Jahre 1768 diente als Symbol
die steile Landstraße hi- heute die Highlights jeder für Rechtsprechung und war
nunter nach Theux. Theux Besichtigung und in ihrer Art Schauplatz für amtliche Ver-
ist einer jener bezaubernden einzig in Europa. Dank neuer lautbarungen. Berühmter ist
Ardennenorte, die den süch- interaktiver Audioguides ihr Pedant in der Lütticher
tig machenden Charme des (auch in Deutsch) und einer Altstadt am Rathaus, das es
Landes, die gastfreundliche, Multimedia-Vorstellung sogar zum Wahrzeichen der
erfrischende Lebensart und können Besucher die Burg Maasmetropole gebracht hat.
die inspirierende Idylle in auf ihre ganz persönliche Das Ortszentrum von Theux. Der sogenannte Perron ist das Zei-
diesen Regionen ausstrahlen. Weise erobern. Im „Au-delà Fortsetzung auf Seite 5 chen für den Schauplatz amtlicher Verlautbarungen.Anzeigensonderveröffentlichung
5
Fortsetzung von Seite 4 halsigen Aktion versuchten, Ein verstecktes Kleinod in der es bis auf die Kreuzung von sich nun in der Region Ourt-
Wenn man nach Theux hi- den Burgunderherzog Karl geheimnisvollen Wallonie. Banneux, dem bekannten he-Amblève (Amel). Sie lässt
neinfährt, kommt man an den Kühnen, den Belagerer Auf der anfangs eingeschlage- Wallfahrtsort. Linkerhand sich zu Fuß, per Rad oder zu
der romanischen Kirche des der Stadt Lüttich, gefangen nen Route (N 62) zurück und dann hinab über die N666 ins Pferd näher erkunden.
Saints Hermès et Alexandre zu nehmen und das mit ihr dann weiter folgend geht Tal der Amel. Man befindet Fortsetzung auf Seite 6
vorbei, die eine echte Entde- ihrem Leben bezahlten. Aus
ckung ist. Es ist eine so ge- Theux heraus an der Kirche
nannte Hallenkirche (drei vorbei hält man sich dann
Schiffe mit gleich hohen, fla- rechts über die N 62 steil
chen Decken) aus dem 11. bergan über Mont Theux bis
Jahrhundert, mit einem mar- auf die Höhe der Kreuzung
kanten, wehrhaften Turm. Sie Banneux. An der Beschilde-
ist die einzige romanische rung Tierpark La Reid (eben-
Hallenkirche zwischen Loire falls sehenswert) empfiehlt
und Rhein. Eine Rarität sind sich vorher linkerhand ein
die flachen Holzdecken, die Abstecher bis zur Kreuzung
mit 127 Holzmalereien aus La Reid/Spa-Remouchamps.
dem 17. Jahrhundert verziert Diese überquert man, um
sind. Sehenswert ist auch nach Hautregard zu „Les
eine Reihe von Skulpturen, Charmilles“ (Beschilderung
die das Kircheninnere zieren, beachten) zu kommen. Am
darunter eine Marienfigur heutigen Institut für Land-
aus dem 15. Jahrhundert. Die wirtschaftskunde der Provinz
Kirche ist von Oktober bis Lüttich, einem ehemaligen
Mai von 10 bis 17 Uhr geöff- Schloss mit einem prächtigen
net und von Juni bis Septem- Bauernhof, gelangt man am
ber von 10 bis 18 Uhr. Gegen- Ende einer schönen Rotbu-
über der Kirche steht ein chenallee zu einem erstaunli-
Denkmal zur Erinnerung an chen Laubengang von 573
die Gefallenen der beiden Metern Länge, den Charmil-
Weltkriege. Hier wird zudem les. Diese dichte Hagebu-
aber auch der 600 Franchi- chenallee, die einem Gewöl-
montois gedacht, die 1468 bebogen aus Pflanzen gleicht,
unter der Führung von Vin- 4 500 an der Zahl, von denen
cent van Bueren (nach ihm mehr als zwei Drittel mindes-
ist die legendäre Treppen- tens hundert Jahre alt sind,
straße in der Lütticher Alt- wurde 1885 von dem Indus- Die prächtige Kirche mit ihrem markanten und wehrhaften Turm wurde im 11. Jahrhundert er-
stadt benannt) in einer wag- triellen J.-R. Nys errichtet. baut und ist ein weithin sichtbares Symbol der Stadt. Foto: Rolf Minderjahn
RENDEZ-VOUS IN
Die gemütliche Kleinstadt am Fusse des Hohen
Blumenstadt 21. Juli – Belgischer
Nationalfeiertag (21/07)
Venns ist bekannt als beliebtes Ausflugsziel in
Schon vor vielen Jahren hat Malmedy
den belgischen Ardennen, mit herausragen-
schon den Titel « Blumenstadt Euro-
den Landschaften, viel Kulturgenuss, echter
pas » getragen. Seitdem verwandelt
Folklore, Feste und Veranstaltungen aller Art,
sie sich jeden Sommer zur Attraktion
sowie ein lebendiger Einzelhandel, zahlreiche
für alle Freunde des Blumenschmucks.
Gasthäuser, ansprechende Hotels, Gästezim-
Der geschichtliche Stadtrundgang
mer, Feriendörfer und eine Jugendherberge.
« Erinnerungen » wird dann zum Das typische Volksfest für Gross und
besonderen Erlebnis. Klein, mit einem riesigen Trödelmarkt
ab 6 Uhr, Musik und Darbietungen
3 Veranstaltungen aller Art im Laufe des Tages bis zum
Feuerwerk am Abend. Da muss man
der besonderen Art
dabei sein !
Der Markt aus der
Provence (10 > 13/05) Das Riesenomelett (15/08)
35 Marktstände mit echten franzö-
Ausstellung « Die Urwelt » sichen Produkten, die die Hersteller
(31/03 > 30/09) aus Südfrankreich persönlich anbieten,
im ehemaligen Kloster belagern die Innenstadt: Oliven,
Olivenöl, Nougat, Wein aus der Pro-
Die einmalige Sammlung von Fotos, vence, Wurstwaren, Käse, Tapenade
Gegenständen und Filmen, des Ethno- und andere Spezialitäten wie typische Die Bruderschaft aus Malmedy
logen und Forschers Jean-Pierre Tischdecken, Handwerkskunst, feiert jedes Jahr dieses Folkorefest
Dutilleux aus Malmedy dokumentiert Lavendel usw. mit den Freunden aus aller Welt.
das Dasein von 13 Volksstämmen in Ab 12 Uhr wird das Riesenomelett
Amazonien, Indonesien, Neuguinea im Freien in einer Riesenpfanne von
und Philippinen auf eine anprechende 4 Metern Durchmesser gebraten
Art und Weise. Die Frage des Überle- und anschliessend kostenlos an die
bens dieser « Urmenschen » steht Zuschauer verteilt. Eine Gaudi der
www.malmedy.be • +32(0)80/799.668 selbstverständlich auch im Raum. besonderen Art. Einmalig in Belgien.6 Anzeigensonderveröffentlichung
Deigné gilt als eines der schönsten Dörfer in der Wallonie. Zahlreiche der Häuser mit Fassaden aus Kalksandstein stehen unter Denkmalschutz.
Fotos: Rolf Minderjahn
Fortsetzung von Seite 5 toir sind kleinen Höhlen (55 ist in verschiedene Teile ge- Bootsfahrt der Welt (700 Me- Thronprätendent der Graf
Nicht weniger als 900 km insgesamt, davon 16 in und gliedert. Zunächst das er- ter). Erlebenswert ist die ein- von Paris, die französische Va-
beschilderte Wanderwege la- um Deigné), in denen die Bä- wähnte Safari-Gelände mit drucksvolle natürliche rietékünstlerin Mistinguett,
den zu einem Ausflug in die che verschwinden, indem sie Elefanten, Flusspferden, Gi- Schönheit der aufeinander- Fernandel, der argentinische
Wälder, durch typische Ort- sofort in der Erde versickern, raffen, Zebras, Wasserbüffeln folgenden Höhlensäle, da- Rennweltmeister Fangio
schaften oder entlang der wenn sie auf die Kalkstein- u.s.w.. Man teilt sich mit eini- runter die „Galerie des Ab- u.v.a.m. sind hier abgestie-
Flüsse ein. Es gibt gut 700 km schicht stoßen. Durch diese gen Tieren quasi die Wege grunds“ oder die „Kathe- gen. Seine originelle naturbe-
Radwege: Radtourismus auf Bäche entsteht der berühmte durch das Gelände. Vor dem drale“. Zu beobachten sind lassene Terrasse mit dem
kleinen ruhigen und maleri- Rubicon, der unterirdische zweiten Bereich stellt man das auch Fledermäuse, die in die- schmiedeeisernen Dach und
schen Routen oder VTT Fluss in Remouchamps, der Auto auf dem großen Park- ser faszinierenden Kulisse den markanten hunderte
(Mountainbiken) auf hügeli- dort durch die Grotten fließt. platz ab. Im Herzen der Park- einen ruhigen Lebensraum Jahre alten Bäumen davor ist
gen Strecken mit spektakulä- Deigné selbst ist sehr klein, anlage beginnt ein Rundgang gefunden haben. In Remou- eine weitere Rarität, wie man
ren Verläufen. Nahezu 150 km aber seine Umgebung hat zu den verschiedensten Tier- champs steht auch einer der sie wohl nur in den Ardennen
Reiterwege in ländlichen Ge- große Sehenswürdigkeiten gehegen mit Löwen, Tigern, altehrwürdigsten Hotel-Res- findet und auch das heutzu-
bieten wie in der wilden Natur wie den Safari-Park „Monde Geparden, Bisons, Affen- taurantbetriebe in der Wallo- tage nur noch sehr selten. Das
sind beschildert. Den Ortsein- Sauvage“ direkt vor der Tür. inseln, Seelöwen-Show. Zum nie (Coverfoto dieses Maga- Haus ist Hotel und Restaurant
gang von Deigné an der N 666 In zwei Minuten mit dem Safari-Park gehören die Grot- zins). Das Hotel Bonhomme zugleich. Die Küche genießt
schmückt den ganzen Som- Wagen erreicht man den Safa- ten von Remouchamps. Frü- ist in diesem Jahr seit sage einen exzellenten Ruf. Fluss-
mer über ein Rondell mit far- ri-Park der „Monde Sauvage“. her Lebensraum der Jäger des und schreibe 250 Jahren und krebse und Forellen, eine wei-
benfroher Blumenpracht, Das Terrain des Safari-Parks Paläolithikums, laden diese sieben Generationen in Fami- tere Besonderheit, kommen
ebenso wie der ganze Ort mit kann mit dem eigenen PKW für Besuche hergerichteten lienbesitz. Die Mauern des aus den kalten Gewässern des
seinen hübschen und oft bes- befahren werden oder man und mit einer märchenhaften Gebäudes aus dem Jahre unterirdisch fließenden Flus-
tens restaurierten Bruchstein- benutzt die kleine touristi- Beleuchtung ausgestatteten 1768, ursprünglich eine Post- ses Rubicon in den Grotten
häuschen aus Kalk- und Sand- sche Wegebahn, die über das Galerien ein zur Entdeckung relaisstation, sind von Ge- gleich nebenan. Das mitunter
stein in eine Blumendekora- Freigelände zwischen den zu Fuß und zur Rückkehr mit schichte geradezu durch- heute etwas kitschig wirkende
tion getaucht wird. Er trägt zahlreichen Tierarten vorbei der Barke auf dem Rubicon, tränkt: der belgische König Interieur ist wahrscheinlich
das Label „Eines der schöns- ruckelt. Die Monde Sauvage der längsten unterirdischen Albert I, der französische Geschmackssache, doch man
ten Dörfer der Wallonie“. Die könnte sich in diesem herrli-
Häuser datieren zum größten chen, alten Gebäude kaum et-
Teil aus dem 18. Jahrhundert. was anderes vorstellen.
Die Fassaden tragen auf Stein-
schildern über der Tür ihr Ge-
burtsdatum und in Nischen Impressum
Heiligenfiguren. Das älteste
Haus stammt aus dem 17. Belgien-Magazin
Jahrhundert, die „Bergerie“ Verlag:
aus Kalksandstein, die unter Zeitungsverlag Aachen GmbH
Dresdener Str. 3
Denkmalschutz steht. Es gibt
52068 Aachen
einige schöne Gassen mit har- 0241/5101-0
monischen Bruchsteinfassa-
Druck:
den, die zu einem kleinen Euregio Druck GmbH
Bummel einladen. An der Kir- Dresdener Str. 3
che stehen Lindenbäume an 52068 Aachen
einem kleinen Brunnen. Es ist Verantwortlich für den Inhalt im
so etwas wie das Zentrum des Sinne des Landespressegesetzes
Dorfes. Es gibt sogar einen NRW:
Menhir in Deigné (beschilder- Jürgen Carduck
ter Weg) und viele geologi- Anschrift siehe Verlag
sche Besonderheiten. Verantwortlich für den Anzeigen-
teil:
Attraktionen unter Jürgen Carduck
und über der Erde Anschrift siehe Verlag
Ein Produkt aus dem
Das Tal hier wird „Vallon des Die Charmilles sind ein Laubengang aus Hagebutten mit mehr als 500 Metern Länge. Sie ent-
Chantoirs“ genannt. Chan- standen im 19. Jahrhundert.Anzeigensonderveröffentlichung
7
Leidenschaft als Philosophie
Lederland: Eine Qualitätsmarke als Erfolgsgeschichte
Lederland ist die Qualitäts- unsere qualifizierten Mit-
marke für Ledersitzgarnituren arbeiter durch unsere Ausstel-
– und sie setzt ihren Erfolgs- lungen.
weg weiter fort. „In unseren Und schließlich profitieren
Ausstellungsräumen wird eine unsere Kunden von unseren
bis dato in Europa noch nie da regelmäßigen Sonderaktio-
gewesene Angebotsvielfalt der nen rund ums Lederland-Sor-
Extraklasse präsentiert“, timent: attraktive Sonderan-
freuen sich daher die Ge- gebote, Eintauschaktionen ge-
schäftsinhaber Joseph Lam- brauchter Sitzgruppen oder
bertz und Werner Havenith. Themenaktionen wie die Ita-
In hellen und freundlichen lienischen Wochen. Das
Ausstellungsräumen findet macht uns so schnell keiner
der Kunde alles, was uns seit Ledermöbel werden immer be- nach!
jeher ausmacht: Qualität, liebter bei den Kunden.
Vielfalt und anspruchsvollste Leder – langlebige
Beratung. Lederland bietet und Mülheim-Kärlich erfolg- Wohlfühlgarantie
dem Besucher alle Trends, Stil- reich. In Belgien zählt Leder-
richtungen, Farben und Le- land zu den größten Ledermö- In jedem dritten Wohnzim- Die Fachleute von Lederland stellen den Kunden individuell und
derqualitäten auf großzügi- belspezialisten des Landes. mer steht heute eine Ledergar- nach Wunsch-Budget ganze Garnituren zusammen.
gem Raum und in anspre- Diese Erfolge ziehen wir aus nitur – uns überrascht das Fotos: Pegasus/Orange Nolte-Polster
chendem Ambiente. Und mit unserer Leidenschaft für das nicht. Denn zum einen hat
den neuesten Modellen, sei es Material Leder, für das Pro- Leder den Vorteil einer un-
die reine Ledercouch oder dukt Ledergarnitur. empfindlichen Oberfläche:
eine geräumige Ledersitz- Und dieser Liebe bleibt Le- Verschütteter Rotwein oder
gruppe, sind wir dabei immer derland bis heute treu: mit Ge- Cola sind für Ledersitzgrup-
topaktuell – eine unvergleich- spür für Trends und umsichti- pen überhaupt kein Problem.
liche Auswahl für Jung und gen Einkäufen auf nationalen Die nach hohen ökologischen
Alt, für jedes Budget und für und internationalen Möbel- Gesichtspunkten gegerbten
jeden Geschmack. messen in Paris, Brüssel, Mai- Oberleder versprechen Lang-
land oder Köln. Diese Leiden- lebigkeit, Wertbeständigkeit
Seit mehr als 40 Jahren schaft ist unsere Philosophie. und auch für Allergiker ein
– die Nummer Eins für Und die lassen wir unsere uneingeschränktes Wohlfühl-
Ledergarnituren Kunden auch spüren – in Ser- erlebnis. Und zum anderen
vice, Beratung und Angebot. besitzt dieses edle Material das
Die Erfolgsstory von Leder- unnachahmliche Flair der Ex-
land beginnt 1976 in Belgien. Die Plus-Punkte: klusivität – egal ob in moder- +32 4 224 49 38
WWW.EUROPAEXPO.BE
Seitdem ist das Unternehmen Beratungsqualität und nem oder klassischem Design.
mit einem einzigen Produkt – Serviceleistung Schauen Sie vorbei und
23/09/2017 > 03/06/2018
der Ledersitzgarnitur – inter- nehmen Sie Platz: Über 40 Le- LÜTTICH GUILLEMINS TGV BAHNHOF
national äußerst erfolgreich. Service geht bei Lederland im- derarten in hunderten Farb-
Und zwar mittlerweile mit mer über den bloßen Verkauf nuancen und über 150 ver-
einer Größe und Angebots- eines Möbelstücks hinaus: Für schiedene Modelle werden Sie
vielfalt, die ihresgleichen uns ist die kostenfreie Liefe- vom natürlichen Material Le-
sucht. rung innerhalb Deutschlands der überzeugen! Was Sie sonst
Lederland verkaufte in selbstverständlich. Auch ein noch über den Aufbau der
Europa bis heute über 800 000 Beratungsgespräch in aller Polsterung und die Verarbei-
Ledergarnituren. Das Unter- Ruhe und entspannter Atmo- tung wissen möchten, erklä-
nehmen ist in Deutschland sphäre gehört bei uns zum ren Ihnen unsere kompeten-
zudem mit vielen weiteren Kauferlebnis einfach dazu. ten Einrichtungsberater. Fin-
Niederlassungen in Saarbrü- Fachkundig und mit Finger- den Sie Ihr ganz eigenes Wohl-
cken, Wiesbaden, Viernheim spitzengefühl begleiten Sie fühlmodell – bei Lederland!
EINE AUSSTELLUNG, DIE MAN GESEHEN HABEN MUSS.
UNSERE ZUKUNFT BILDLICH DARGESTELLT!
M. LECLERCQ (FACEBOOK).
Der perfekte Ort nach einem anstrengenden Arbeitstag: eine schicke und hochwertige Leder-
couch lädt zum Entspannen und Wohlfühlen ein.8 Anzeigensonderveröffentlichung
Moonwalk in den Ardennen
Das einzige Space-Center Europas liegt im Süden Belgiens
Von Rolf MindeRjahn tionen erleben, nicht alle all die Instrumente begutach-
Tage. Im Modul der ISS faszi-
ten. Eine Menge Action ver-
Mit Erstaunen blickt man auf nieren die Erläuterungen dessprechen die „Mutproben“
die futuristisch anmutende Guides Robert Schewijck. wie der Moonwalk-Simulator,
Anlage, die originalgetreue „Natürlich wollen die Leute bei dem man selbst die Kräfte,
Europa 2 Rakete (Vorläuferin wissen, wie und wo die Astro-
die beim schwebenden Gang
der Ariane), auf Sputnik-Satel- nauten schlafen“, betont über die Mondoberfläche zu
liten, die Trägerrakete der Schewijck und öffnet eine Tür-
bewältigen sind, nachempfin-
Ariane 4, die alle mitten in klappe in der Wand. Dahinterden kann. Oder der Rotations-
den Ardenner Wäldern, un- verbirgt sich eine winzige simulator, der die mögliche
mittelbar an der E411 Namur- Schlafkammer. „Betten gibt es
Orientierungslosigkeit im
Arlon, stehen. Wer hätte das natürlich nicht, in der Tat Weltall durch permanente
gedacht, ein Raumfahrtzen- schlafen die Astronauten Drehbewegungen in alle Rich-
trum im Süden Belgiens, das quasi in der Vertikalen hän-tungen simuliert. „Alle diese
einzige in Europa dieser Art, gend“, sagt er. Durch eine Geräte sind vollkommen un- Hier kann man ein nachgebautes Space-Shuttle in Original-
und das man auch live erleben Raumstation zu gehen, ist gefährlich“, betont der Guide. Größe besichtigen. Foto: WBT/J.P.Remy
kann. Es ist eine besondere wirklich ein Erlebnis. Das glei-
Das Space Center ist vor allem
touristische Attraktion, in der che gilt für den Blick auf das
auch für Kinder und Schul- Planetarium, einem Kuppel- fahrt in unser tägliches Leben
die Besucher vieles entdecken Space Shuttle und seine riesi-
gruppen hochinteressant bau, in dem die Erforschung Einzug gehalten haben. Im
und eine Menge über die gen Triebwerke. Auch hier (Gruppen können auch in der des Weltalls in einer interes- Außengelände gibt es einen
Menschheitsmission in Sa- wird ein Einblick ins Cockpit
Jugendherberge vor Ort über- santen Filmanimation auf sogenannten Weltraumspa-
chen Weltall lernen können. gewährt, unglaublich in wel-nachten), der Lernfaktor ist amüsante und lehrreiche Art ziergang „Made Ardennen“ an
Ein originalgetreuer Nach- cher Enge die acht Besat- groß. Es gibt eine Menge an und Weise vermittelt wird. der frischen Luft über 6 km
bau eines Moduls der ISS zungsmitglieder, vier oben im
Programmen vom Weltallwo- Der Rundgang mit Audio- durch Wiesen, Gehölze,
Raumstation zählt ebenso zu Steuerungscenter und vier chenende für die Familie bis Guide wie auch die Führun- Hochwald und Tannenbe-
den Highlights wie das in Ori- unten in der Kabine, auskom-zum Astronautentraining für gen werden in deutscher Spra- stände. Er ist Teil der Space
ginalgröße nachgebaute men müssen. Jedermann. Multimedial geht che angeboten. Es gibt Wech- Odyssee und eines großen Ra-
Space Shuttle in den riesigen es überall zu. Vor allem auf selausstellungen zu verschie- tewettbewerbs.
Hallen des Centers. So nah Einmal Astronaut sein dem Rundgang mit Audio- denen Themen wie beispiels-
kommt man der Raumfahrt Guides (auch in Deutsch) weise die aktuelle, die sich den
und dem, was die Menschen
in den Shuttles und Raumsta-
Man darf sich ins Cockpit durch die Geschichte des Pla-
einer Raumkapsel setzen und netensystems. Oder etwa im
Materialien und Entwicklun-
gen widmet, die aus der Raum- ? Mehr Informationen:
www.eurospacecenter.be
Anzeigensonderveröffentlichung
Fit in den Frühling mit Spargel
Roger Trost vom Restaurant Saveurs du Tilleul, welches dieses Jahr 10-jähriges feiert, empfiehlt unseren Lesern zum Nachkochen:
Spargel mit Parmaschinken, Pfannkuchen,
Cremoso und Bärlauch
B-4728 HERGENRATH
Zutaten für 4 Personen cker bissfest kochen. (Den grünen Spargel in
200 g Mehl Eiswasser kurz abschrecken) Aus Mehl, Milch, Kreative, saisonale Küche
3 Eier Eiern, Salz und einem Schuss Mineralwasser mit französischen Anklängen
und regionalen Produkten
1Schuss Mineralwasser einen glatten Teig rühren. Vier Pfannkuchen Erlesene Weine in
1 dl Milch (+/- 20 cm Durchmesser) in Butter ausbacken großer Auswahl
Salz, Pfeffer nach Belieben und warm stellen. Mit „Fond de Loge“ Angebote
1 Prise Zucker frischer Bärlauch nach Belieben Spargel auf die Pfannkuchen geben. Darüber
Une cuisine
(oder 1TL Bärlauchpesto) Für die Soße die Parmesanhobel streuen. de qualité
2dl Sahne 150 g Cremoso Käsemischung 2 dl Spargelsud, Sahne und Cremoso erhitzen
(Galbani) oder zur Hälfte Gorgonzola und (nicht kochen), geriebenen Parmesan unter- Dazu passt ein schöner Wildblattsalat an
Mascarpone rühren und mit Salz und Pfeffer abschmecken. Olivenöldressing mit hellem Balsamico Essig.
75 g frisch geriebener Parmesan Die Soße soll ziemlich dickflüssig
dickflüssig sein. Eventu-
Parmesanhobel nach Belieben ell mit etwas Soßenbinder leicht eindicken. Bon appétit!
12 Scheiben dünn geschnittener Parma-
schinken Fertigstellung
16 fingerdicker weißer oder grüner Stangen Die Pfannkuchen auf vorge-
Spargel wärmte Teller geben.
www.saveurs-du-tilleul.com
Dann Parmaschin-
(2 Bestecke - Guide Michelin 2018)
Zubereitung ken, Soße, feine Asteneter Str. 19 | 4728 HERGENRATH
Den Spargel schälen und in Wasser mit einem Bärlauchstreifen Tel. & Fax: + 32 (0)87/46 36 46
E-Mail: traiteurroger@gmail.com
Stück Butter, Salz und einer kleinen Prise Zu- und den warmen Öffnungszeiten:
Donnerstags bis Montags mittags ab 12 abends ab 18Uhr
(Küchenz. 12-14 Uhr/18-21 Uhr ) Di. & Mi. geschlossenAnzeigensonderveröffentlichung
9
Tourenbike, E-Bike oder MTB – Qual der Wahl in Ostbelgien
Ein dichtes Wegenetz ermöglicht ganzjährig Touren für jeden Geschmack und jede körperliche Ausdauer
Mit dem Tourenbike, dem E- grenzüberschreitende Natur- durch Hügel und Täler und an lassen Sie sich an die schöns- Bed&Bike-Unterkünfte Sie
Bike oder dem Mountainbike paradiese. Flache Streckenver- Flüssen entlang, über Via- ten Fleckchen Ostbelgiens herzlich willkommen. Achten
lässt sich Ostbelgien wunder- läufe mit sanften Steigungen dukte und durch Tunnel hin- entführen. Sie auf die blau-gelbe Plakette
bar erkunden. Von extremen erwarten Sie. Fernab vom lau- durch. Entdecken Sie entzü- Neigt der Tag sich dem des ADFC.
Radtouren bis hin zum ent- ten Straßenverkehr radeln Sie ckende Städte und Dörfer, und Ende zu, heißen zahlreiche
spannten Radeln findet sich Individuelle Radpauschale
im dichten Wegenetz Ostbel- Ostbelgien
giens für jeden Radtyp die per-
fekte Strecke. Das VeloTour- Unter dem Motto „Entspannt
Radwegenetz beispielsweise, reisen“ bietet die Tourismus-
mit einer Ausdehnung von agentur Ostbelgien Pauschal-
850 km, kann nach dem Kno- angebote, für Kurzurlauber
tenpunktsystem befahren und Wochenendtouristen,
werden und speziell für Moun- von 3 bis 7 Tagen an. Reisen Sie
tainbiker stehen 18 Routen, mit kleinem Gepäck und der
mit einer Gesamtlänge von Gewissheit, dass am nächsten
480 km zur Verfügung. Dies Etappenziel für alles gesorgt ist
reicht von kurzen Strecken bis (www.ostbelgien.eu/radpau-
zu technisch und körperlich schalen). Gerne erarbeiten wir
anspruchsvollen Routen. auch individuell mit Ihnen
eine Radpauschale, die Ihren
Ostbelgiens Qualitätsradroute Vorstellungen entspricht.
– Die Vennbahn
Der Allgemeine Deutsche
Fahrradclub ADFC bestätigt, Weitere
die Vennbahn ist eine Quali- Informationen
tätsradroute und verleiht dem
Radweg entlang ehemaliger Tourismusagentur Ostbelgien
Eisenbahntrassen ein 4-Ster- Hauptstraße 54 | B-4780 St.
ne-Gütesiegel. Die Vennbahn Vith | T: +32 (0)80 22 76 64|
führt, ausgehend von Aachen, M: info@ostbelgien.eu www.
durchs Hohe Venn, gerade- Der Vennbahn-Radweg ist ideal für einen Ausflug mit der ganzen Familie. ostbelgien.eu
wegs durch ostbelgische und Foto: Wolfsbusch/Montenau/ Vennbahn – Dominik Ketz www.vennbahn.eu
Sportlich, rasant oder gemütlich –
Ostbelgien entdecken
Radreisen ohne Gepäck ab 205 € pro Person
2 Übernachtungen in einer Bed&Bike-Unterkunft inkl.:
• Frühstück und Abendessen
• Lunch-Paket für Unterwegs
• Kartenmaterial
Auf Anfrage: Gepäcktransfer zum nächsten
Willkommen in Europas
kraftvollem Garten.
Übernachtungsort, Taxitransfer
Bienvenue dans
le surprenant jardin
de l’Europe.
Welkom in de ruige
tuin van Europa.
© Foto: ostbelgien.eu / D.Ketz
Infos und Reservierungen:
Tourismusagentur Ostbelgien
Hauptstraße 54 | B-4780 St.Vith | T: +32 (0)80 28 09 97
caroline.massotte@ostbelgien.eu
www.ostbelgien.eu www.liegetourisme.be10 Anzeigensonderveröffentlichung
Große Ausstellung „Viva Roma“ in Lüttich
Die neue Ausstellung im La Boverie, dem Museum der Schönen Künste. Eine Zusammenarbeit mit dem Louvre Paris.
Von Rolf MindeRjahn Bürgertums zum guten Ton,
durch Mitteleuropa, Italien,
Rom und die Kunst. Rom und Spanien und auch ins Heilige
die Menschen. Rom und das Land zu reisen.
Leben. Das ist Nahrung für die
Phantasie. Künstler, Kreative Das Leben der Bürger
und die vermögende Elite aus
Europa zog es schon immer Besonders in England erfreute
wie von einer Magie verzau- sich die Grand Tour großer Be-
bert in diese Stadt. Was macht liebtheit. Aber auch das tägli-
die Faszination Roms aus? che Leben der Bürger von Rom
Und wie verbrachten Reisende wird näher beleuchtet. Dieses
ihre Zeit in der ewigen Stadt? war beliebtes Motiv der Male-
Diesen und anderen Fragen rei zwischen dem 17. und 20.
geht die Ausstellung „Viva Jahrhundert.
Roma!“ im Lütticher La Bove- Genau wie die monumen-
rie auf den Grund, die in Zu- talen Sehenswürdigkeiten, die
sammenarbeit mit dem Lou- viele Künstler inspirierten
vre Museum entstanden ist. und bis heute dafür sorgen,
Ein Fokus liegt dabei auf der dass Rom einer der touristi-
„Grand Tour“: Ende des 17. schen Magnete Europas ist.
Jahrhunderts gehörte es für Die Ausstellung beschäftigt
Söhne des europäischen Adels sich zudem mit den Künst- Das Gebäude des La Boverie Museums wurde für die Weltausstellung 1905 errichtet.
und später des gehobenen lern, ihren Verbindungen Foto: R. Minderjahn
untereinander, ihren Freund- lettanti], Exkursionen. „Le setzt das Konzept um. Der Pa-
schaften und ihren Treffpunk- beau pittoresque“, Ankunft, riser Louvre und La Boverie
ten (Cafés, Gasthäuser, Vil- die Alpen zwischen Drama unterzeichneten 2016 einen
len). „Viva Roma!“ erzählt so- und Stereotyp). Vertrag über die partner-
mit die Geschichte hinter schaftliche Organisation und
dem Kunstwerk: überra- Die Partnerschaft mit die Realisierung von zunächst
schend und zugleich wissen- dem Louvre Museum drei großen Ausstellungen
schaftlich fundiert. Kuratoren internationalen Formats. Die
der Ausstellung sind Vincent Das imposante Gebäude des erste im Mai 2016 war zu-
Pomarède und Aline François- La Boverie Museums, das für gleich die Eröffnungsausstel-
Colin vom Louvre Museum. die Weltausstellung von 1905 lung des La Boverie: „En plein
errichtet wurde, glänzt seit air“ versammelte rund 130
Struktur der Ausstellung: dem Frühjahr 2016 als kultu- Werke, die von internationa-
Die Ausstellung ist in vier Teile reller Meilenstein wie ein klei- len Institutionen und weltbe-
gegliedert: ner Louvre für Lüttich. rühmten Museen zur Verfü-
In diesem Palais mit seinen gung gestellt wurden. Sie wid-
1. Einleitung (Motivation, majestätischen Sälen und im- mete sich der zeitgenössi-
Antike, die Renaissance kopie- posanten Säulen ist das Mu- schen Darstellung von Aktivi-
ren, Licht[er], Religion) seum der Schönen Künste von täten im Freien und der Ent-
2. Geschmack der Antike (Aus- Lüttich zu Hause, erweitert stehung des Impressionismus.
grabungen, die Faszination um einen neuen Bereich für Mit dieser zweiten Zusam-
des Forums, Führung im Ko- temporäre, facettenreiche menarbeit „Viva Roma“ ha-
losseum, Wandel vom einen Ausstellungen mit großer ben Lüttich und Paris für
Rom zum anderen) Strahlkraft weit über die Gren- einen weiteren Kunstgenuss
3. Vergnügen in Rom (Karneval, zen hinaus. Insgesamt bietet gesorgt, auf den sich ein inter-
Freunde, Gasthäuser und Vil- es rund 4200 Quadratmeter nationales Publikum freuen
len, die Banditen als künstleri- Ausstellungsfläche. darf.
sches Phänomen) Der renommierte französi- Die Ausstellung ist vom 24.
4. Grand Tour (Amateure [Di- sche Architekt Rudy Ricciotti April bis 26. August zu sehen.
Das nächste Belgien-Magazin
erscheint am 29. September 2018
Ihr Mediaberater
Susanne Royé
Kontakt
Tel. 02472 9700-21 · Fax 02472 9700-29
E-Mail susanne.roye@medienhausaachen.de
Ihre Mediaberaterin
Ruth Steffens
Kontakt
Tel. 02472 9700-22 · Fax 02472 9700-28
E-Mail ruth.steffens@zeitungsverlag-aachen.de
Ein Werk der Ausstellung „Viva Roma!“ zeigt das Forum Romanum.
Foto: Stirling Smith Art Gallery and MuseumAnzeigensonderveröffentlichung
11
Lüttich verwandelt sich in eine Freilichtbühne
„Métamorphoses“ vom 9. bis 13. Mai – Das Festival der Performances in der Metropole
Von Rolf MindeRjahn Highlights, die unter die Haut Chloé Moglia – „Horizon“: laden sie zu einer gemeinsa- Abend, Herstal, Feuer als
gehen. Schwindelgefühle und Ba- men Flow Session ein, um die Kunstwerk
„Métamorphoses“ steht für lance. Mit einem besonderen Vibrationen der Kohäsion und
die poetische und künstleri- Donnerstag, 10. Mai Hilfsmittel, „La Courbe“ ge- der bewusstseinsbildenden Be- Donnerstag, 10. Mai – Wäh-
sche Darstellung des frischen Park La Boverie – Ein Tag im nannt, fordert Chloé Moglia wegung zu teilen. rend 4 Tagen, Lüttich, Espace
Winds, der über Lüttich weht. Zeichen des Zen, nachmittags die Gesetze der Schwerkraft he- Tivoli, ein ungewöhnlicher
Ein völlig kostenloses, fünftä- raus. Ihre 6 m hohe Rampe Samstag, 12. Mai Gast…
giges Festival, wird die ge- Der von Maas und Dérivation lässt sie an allen möglichen Lüttich – Stadtspaziergang
samte Metropole in einen umarmte Boverie-Park ist ein und unmöglichen Orten in einmal anders Donnerstag, 10. Mai – Tags-
Rausch versetzen. Überra- bevorzugter Ort für Spazier- den Himmel ragen. Eine un- über, Lüttich, Park La Boverie,
schende und märchenhafte gänge. Ganz „zen“ präsentiert glaubliche, schwindelerre- Place du XX Août, 13.00 Uhr im Zeichen des Zen
künstlerische Darbietungen sich der Park an diesem Tag gende Performance. Große Durch Lüttichs Straßen zie-
finden dabei unter freiem dank einer feinen Auswahl von Yoga Community: Tausende hen. L’Echappée Urbaine ist Samstag, 12. Mai – Tagsüber
Himmel statt. „Métamorpho- Performances, die Augen, Oh- Yogis versammeln sich im Parc ein musikalisch untermalter und am Abend, Lüttich, die
ses“ ist ein Event, das symbol- ren und Tastsinn ansprechen. de la Boverie. Gleich gekleidet, Spaziergang. Unterwegs trifft künstlerische Rambla Yser,
trächtige Orte wählt, um zu der Umzug auf verschiedene Constitution, Baviere (Outre-
verblüffen: In Herstal, im Darbietungen, auf Installatio- meuse)
Espace Tivoli, im Parc de la nen und Tänze, auf Poesie und
Boverie, in Seraing, in Chaud- Wissen... Zu den Klängen einer
fontaine und in allen übrigen entfesselten Fanfare erscheint Die märchenhafte Verzaube-
teilnehmenden Gemeinden. das, was wir als Gewissheit hin- rung von Seraing
Die Stadt und ihre Außenbe- nahmen, plötzlich in einem
zirke wandeln sich zu einer anderen Licht. Eine Veranstal- Lüttich – Stadtspaziergang
Freilichtbühne. Métamor- tung der Maison des Sciences einmal anders
phoses 2018: Bei der diesjäh- de l’Homme (Lütticher Univer-
rigen Auflage präsentiert die sität ULiège) und der asbl Son- Sonntag, 13. Mai – Tagsüber
Stadt eine breite Palette von ges in Partnerschaft mit Liège Happy Sunday in Chaudfon-
Kunstformen mit Vorführun- Créative, UniverSud und Ré- taine
gen im Zeichen des Feuers jouisciences.
und des Wassers, des Gleich-
gewichts und des Wohlbefin- Terminkalender:
dens, des Staunens und des Die Besucher erwarten zahlreiche künstlerische Vorführungen.
Schauderns. Künstlerische Foto: R. Niessen
Mittwoch, 9. Mai: Eröffnung
von „Métamorphoses“ – Am ? Mehr Informationen
www.liegetogether.be
RELAX 2000 Ihrer
Gesundheit ZIRBEN-AKTIONSWOCHEN
zuliebe!
26.03. bis 14.04.2018
rper für
3D-Spezialfederkö assung
perfekte Kö rp era np Natürl
ich schlafen. Besser leben
.
Kommen Sie bis zum 14.04. zum Probelie-
€ 150,00 gen und Sie sparen € 150,00 beim Neukauf
Kommen Sie bis zum 20.04. zum Probeliegen
GUTSCHEIN
eines
undRelax 2000 mit
Sie sparen Matratzebeim
€ 150,00 und Auflage.
Neukauf
Das original SCHLAFSYSTEM für Ihren gesunden Schlaf. Aktion gültig bis 14.04.2018 bei Neuaufträgen! Nicht in bar ablösbar. Kann nicht mit anderen Aktionen, Kis
Skontierungen und Rabatten kombiniert werden. Pro Einkauf ist nur ein Gutschein pro Person einlösbar.
98,6 % der Kunden bewerten das Relax 2000 positiv.
Herbesthaler Straße, 281
100 % natürli und in erhältlich!
B-4700 Eupen
Tel. :+32 (0) 87 301 201
info@dodomax.be
www.dodomax.be
Natur-Bettsystem RELAX 2000
0
Wer gesund schläft hat
at mehr
m h vom Leben
Wer dauerhaft schlecht oder zu wenig schläft, beeinträchtigt seine Lebensqualität und strapaziert
seine Gesundheit. Die Herausforderungen des Alltags einerseits und belastende Umwelteinflüsse
andererseits lassen dem gesunden, erholsamen Schlaf zusehends mehr Bedeutung zukommen.
„Allein schon der Umstand, dass und damit unsere Lebensquali- Forstwirtschaft. Das einzigarti-
wir rund ein Drittel unserer Le- tät.“ Familie Dütz erklärt: „Mit ge Bettsystem wird wahlweise Seit 30 Jahren ist das Familienunternehmen
benszeit schlafend verbringen“, dem innovativen Bettsystem in Buchen- oder Zirbenholz ge- Ihr Partner für den gesunden Schlaf.
erklärt Familie Dütz, Experten RELAX 2000 des Naturbetten- fertigt.“
für gesundes Schlafen, „zeigt, herstellers RELAX Natürlich Kernstück des RELAX 2000 ist Schulter-, Nacken- und Becken- gespräch über alle Vorzüge des
wie wichtig das Thema ist. Ge- Wohnen GmbH dominiert die das innovative „Tellersystem“ bereich sowie die Bandscheiben Bettsystems RELAX 2000“, lädt
sunder Schlaf steigert unsere Natur den Schlafbereich und mit seinen einzigartigen Spe- werden entspannt. Zigtausende Familie Dütz Interessierte zu
Leistungsfähigkeit, unsere Vi- sorgt fortan für natürlichen, er- zialfederkörpern, von denen begeisterte Benutzer eines RE- sich ein. „Erfahren Sie bei einem
talität und unser Wohlbefinden holsamen Schlaf. Das Schlafsys- sich jeder einzelne perfekt der LAX 2000 Bettsystems haben so Probeliegen, wie RELAX 2000
tem RELAX 2000 ist Schlafposition, den Bewegun- ihre Schlaf- und damit auch ihre dank seiner perfekten Ergono-
vollkommen metall- gen und der Körperform an- Lebensqualität maßgeblich ge- mie Ihren Schlafkomfort und
frei, das verwendete passt. Dank dieser optimalen steigert. damit Ihre Lebensqualität stei-
Holz unbehandelt Ergonomie, wird die Wirbel- „Gerne informieren wir Sie in gern kann.“
und aus nachhaltiger säule perfekt entlastet, auch einem persönlichen Beratungs-*Außer neue Kollektion. Nicht kumulierbar mit anderen Rabattaktionen.
Ver. Her.: European Living Comfort sa · Herbesthalerstraße 150 · B-4700 Eupen · design www.pavonet.be
VIE RE N ,
IR RENO U S !*
W US S R A
AL LES M BIS ZU
60%
GERÄUMT !
ESCHÄFT WIRD
BE G
DAS HAL
HLASS !
C
PREISNA
Wir bauen um und Sie profitieren!
profitieren!
Mehr als 100 Ausstellungsmodelle
stark reduziert und sofort lieferbar.
Greifen Sie jetzt zu!
LEDERLAND EUPEN · WWW.LEDERLAND-EUPEN.BE
Herbesthaler Straße 150 · B-4700 Eupen · +32 (0)87 59 84 04 · eupen@lederland.info · www.lederland-eupen.be · Täglich von 10 bis 18.30 Uhr · Auch sa. und so.Sie können auch lesen